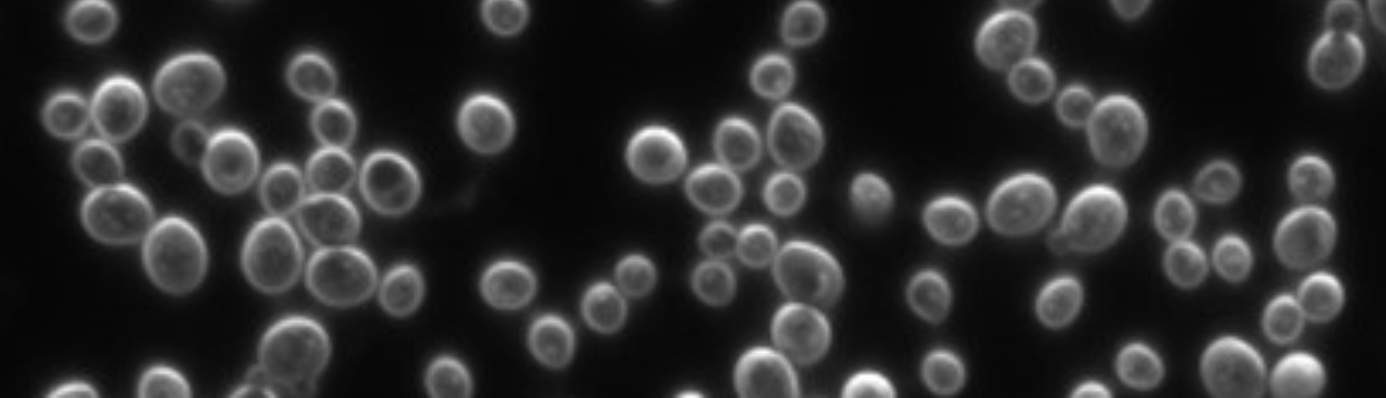
Michael Desai's lab

Verified
Carlos Argüelles
Carlos Argüelles
We study high-energy neutrinos using experiments like IceCube and develop new methods for detecting rare particle physics events.
Research Area
Particle Astrophysics
Sample Projects
- •Selecting high-energy neutrino events in IceCube with boosted decision trees
- •Machine learning to separate signatures in neutrino telescopes